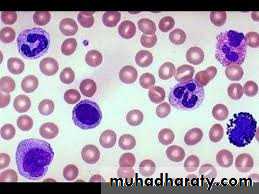

DIFFERENTAIL WBC COUNT
Introduction & principleThe differential WBC count is performed to determine the relative number of each type of WBC in the blood. In disease states a particular white blood cell type shows increase in number in the blood.
Methods
Manual methodElectronic cell counter
Manual differential white cell count material and instruments
Whole blood using EDTA as anticoagulant or capillary blood drawn from a finger or toe puncture.Glass slide
Microscope
Alcohol 70%
Lancet
Leishman's stain – it's composition:
Leishman's stain 0.15 g
Methyl alcohol 100 ml
Immersion oil.
Procedure
Prepare the blood smear
Clean two slide, one to be covered with the blood film and one to be used as spreader.
Clean the finger with alcohol, allow it to dry and then prick it with a disposable lancet to obtain a drop of blood.
Make a fine touch of one end of a slide with the drop of blood (only a small amount is required).
Place the edge of the other slide on the surface of the first slide just in front of the drop of blood and at an angle of 45˚.
Draw the spreader back until it makes contact with the drop of blood.
Push the spreader slowly and smoothly to the other end of the slide in one motion.
Allow the film to dry at room temperature i.e. the blood smears should be air-dried
They should be also labeled immediately with the student's name and the date at the end of slide.
Staining the blood smear by:
Put the dried slide on a staining rack.
The blood smear should be stained as soon as possible certainly within 1 to 2 hours.
Carefully drop Leishman's stain onto the blood film until the film is covered.
Allow the stain to act for one to two minutes.
Add distilled water to the stain, this gives dilution of 1:1 or 1:2
The diluted stain should act for 15-30 minutes
Then wash it off with distilled water, continue washing until the film has a pink color.
Shake off excess water and allow it to dry at room temperature.
Examination of the stained smear
For examining the blood smear a microscope with a low-power objective (10 x) and an oil immersion objective (100 x) is necessary.
Place the slide (smear side up) on the microscope stage.
Examine the blood smear using the low power (10 x) objective. Choose an area where there are plenty of WBCs.
Place a drop of immersion oil on the selected site and carefully change to the oil immersion objective (100 x)
Perform the differential cell count and, at the same time examine the morphology of the WBCs.
Calculation
Count each WBC seen and record on a differential cell counter until 100 WBCs have been counted. For instance, if 25 of the 100 WBCs where lymphocytes, then the percentage of lymphocytes is 25% & so on.
The normal range percentage of the different types of WBCs is as follows:
Neutrophils 50-70%Eosinophils 1-4%
Basophils 0.4%
Monocytes 2-8%
Lymphocytes 20-40%
Neutrophils
Neutrophilia is an increase in neutrophils. Neutropenia is a decrease in neutrophils.Common Causes of Neutrophilic Leukocytosis:
This is seen in any acute insult to the body (both infectious and non-infectious).
Infections (especially) bacterial
Inflammatory disorders (non-infectious) such as rheumatic fever, rheumatoid arthritis.
3, pregnancy, exercise and nervousness due to movement of marginated neutrophils to enter the blood stream.
4.Myeloproliferative disordes.
Causes of Neutropenia (decreased neutrophils):
Problem in the production of neutrophils in the bone marrow which may be congenital, bone marrow failure, radiation, and chemotherapy.
Increased destruction of neutrophils which can be due to the body's immune system targeting neutrophils for destruction. This may be related to having autoimmune diseases, such as systemic lupus erythmatosus It can be also due to large spleen (hypersplenism)
Nutritional such as anorexia nervosa (starvation)
Infections as in bacterial infection such as typhoid fever, or viral infections such as measles, influenza or infectious hepatitis.
Eosinophils
Causes of Eosinophilic Leukocytosis (increase eosinophil):Allergies (most common)
parasites (second most common cause)
Other disease states: Such as scarlet fever, acute rheumatic fever, irradiation.
Eosinopenia (low eosinophil count) may be produced by an elevated secretion of corticosteroids (in states of sever stress).
Basophils
Causes of basophilia include:Myeloproliferative disease and hemolytic anemia.
Allergic reactions
Chicken pox.
Monocytes
Causes of Monocytosis (increased monocytes)Recovery phase of acute infection
Chronic inflammatory disorders such as tuberculosis, malaria,syphilis, brucellosis.
Hematologic neoplasms
Lymphocyte
Causes of Lymphocytosis (increased number/percentage of lymphocytes): It is of two types:
[A] Relative: Total number of circulating lymphocytes unchanged but WBC count low due to neutropenia. Relative lymphocytosis is normal in infants and children (aged 4 months - 4 years). Causes of relative lymphocytosis include: age less than 2 years; acute viral infection, and splenomegaly with splenic sequestration of granulocytes.
[B] Absolute: Number of lymphocytes increases.
Lymphocytic leukemia (most common)Acute viral infections such as measles, rubella, chicken pox, pertussis. Lymphocytosis is a feature of infection, particularly in children.
Some Bacterial infection such as Pertussis (whooping cough).
some protozoal infections, such as toxoplasmosis .
Causes of lymphopenia (decreased number of lymphocytes):
Characteristic of AIDSRecent temporary infection, such as the common cold.
Radiation (lymphocytes most sensitive to whole-body irradiation).
Corticosteroid use.